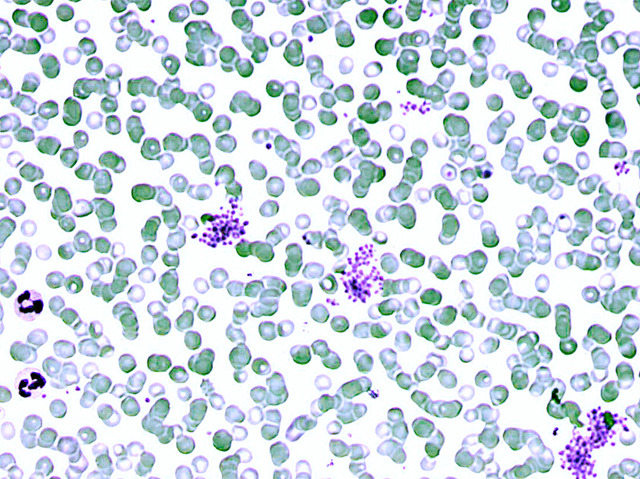

30 December 2014
Parasite Poo Detector
When the malaria-causing Plasmodium parasite chomps through red blood cells, it leaves a tell-tale trace of magnetic poo as it digests iron-rich haemoglobin. The discovery that this waste product, called haemozoin, can be detected by Magnetic Resonance Relaxometry (MRR) scanning has created the intriguing possibility of a new test for the disease. More than 200 million people are infected with malaria each year and many die because regions where it’s endemic lack the facilities for diagnosis. A standard test is to examine a smear of blood under a microscope – pictured is a sample showing dots, stained purple, that are characteristic of blood cells infected with two common varieties of Plasmodium. Scientists who developed the magnetic scanning test claim it could provide a simpler, faster, more accurate and cheaper alternative to the existing method.
Written by
- Image by Osaro Erhabor
- Usmanu Danfodiyo University, Nigeria
- Copyright held by original author
- Research published in Nature Medicine, August 2014
Search The Archive
Submit An Image
Like us on Facebook
Follow on Twitter
Follow on Tumblr
Follow on Instagram
What is BPoD?
BPoD stands for Biomedical Picture of the Day. Managed by the MRC Laboratory of Medical Sciences until Jul 2023, it is now run independently by a dedicated team of scientists and writers. The website aims to engage everyone, young and old, in the wonders of biology, and its influence on medicine. The ever-growing archive of more than 4000 research images documents over a decade of progress. Explore the collection and see what you discover. Images are kindly provided for inclusion on this website through the generosity of scientists across the globe.
BPoD is also available in Catalan at www.bpod.cat with translations by the University of Valencia.








